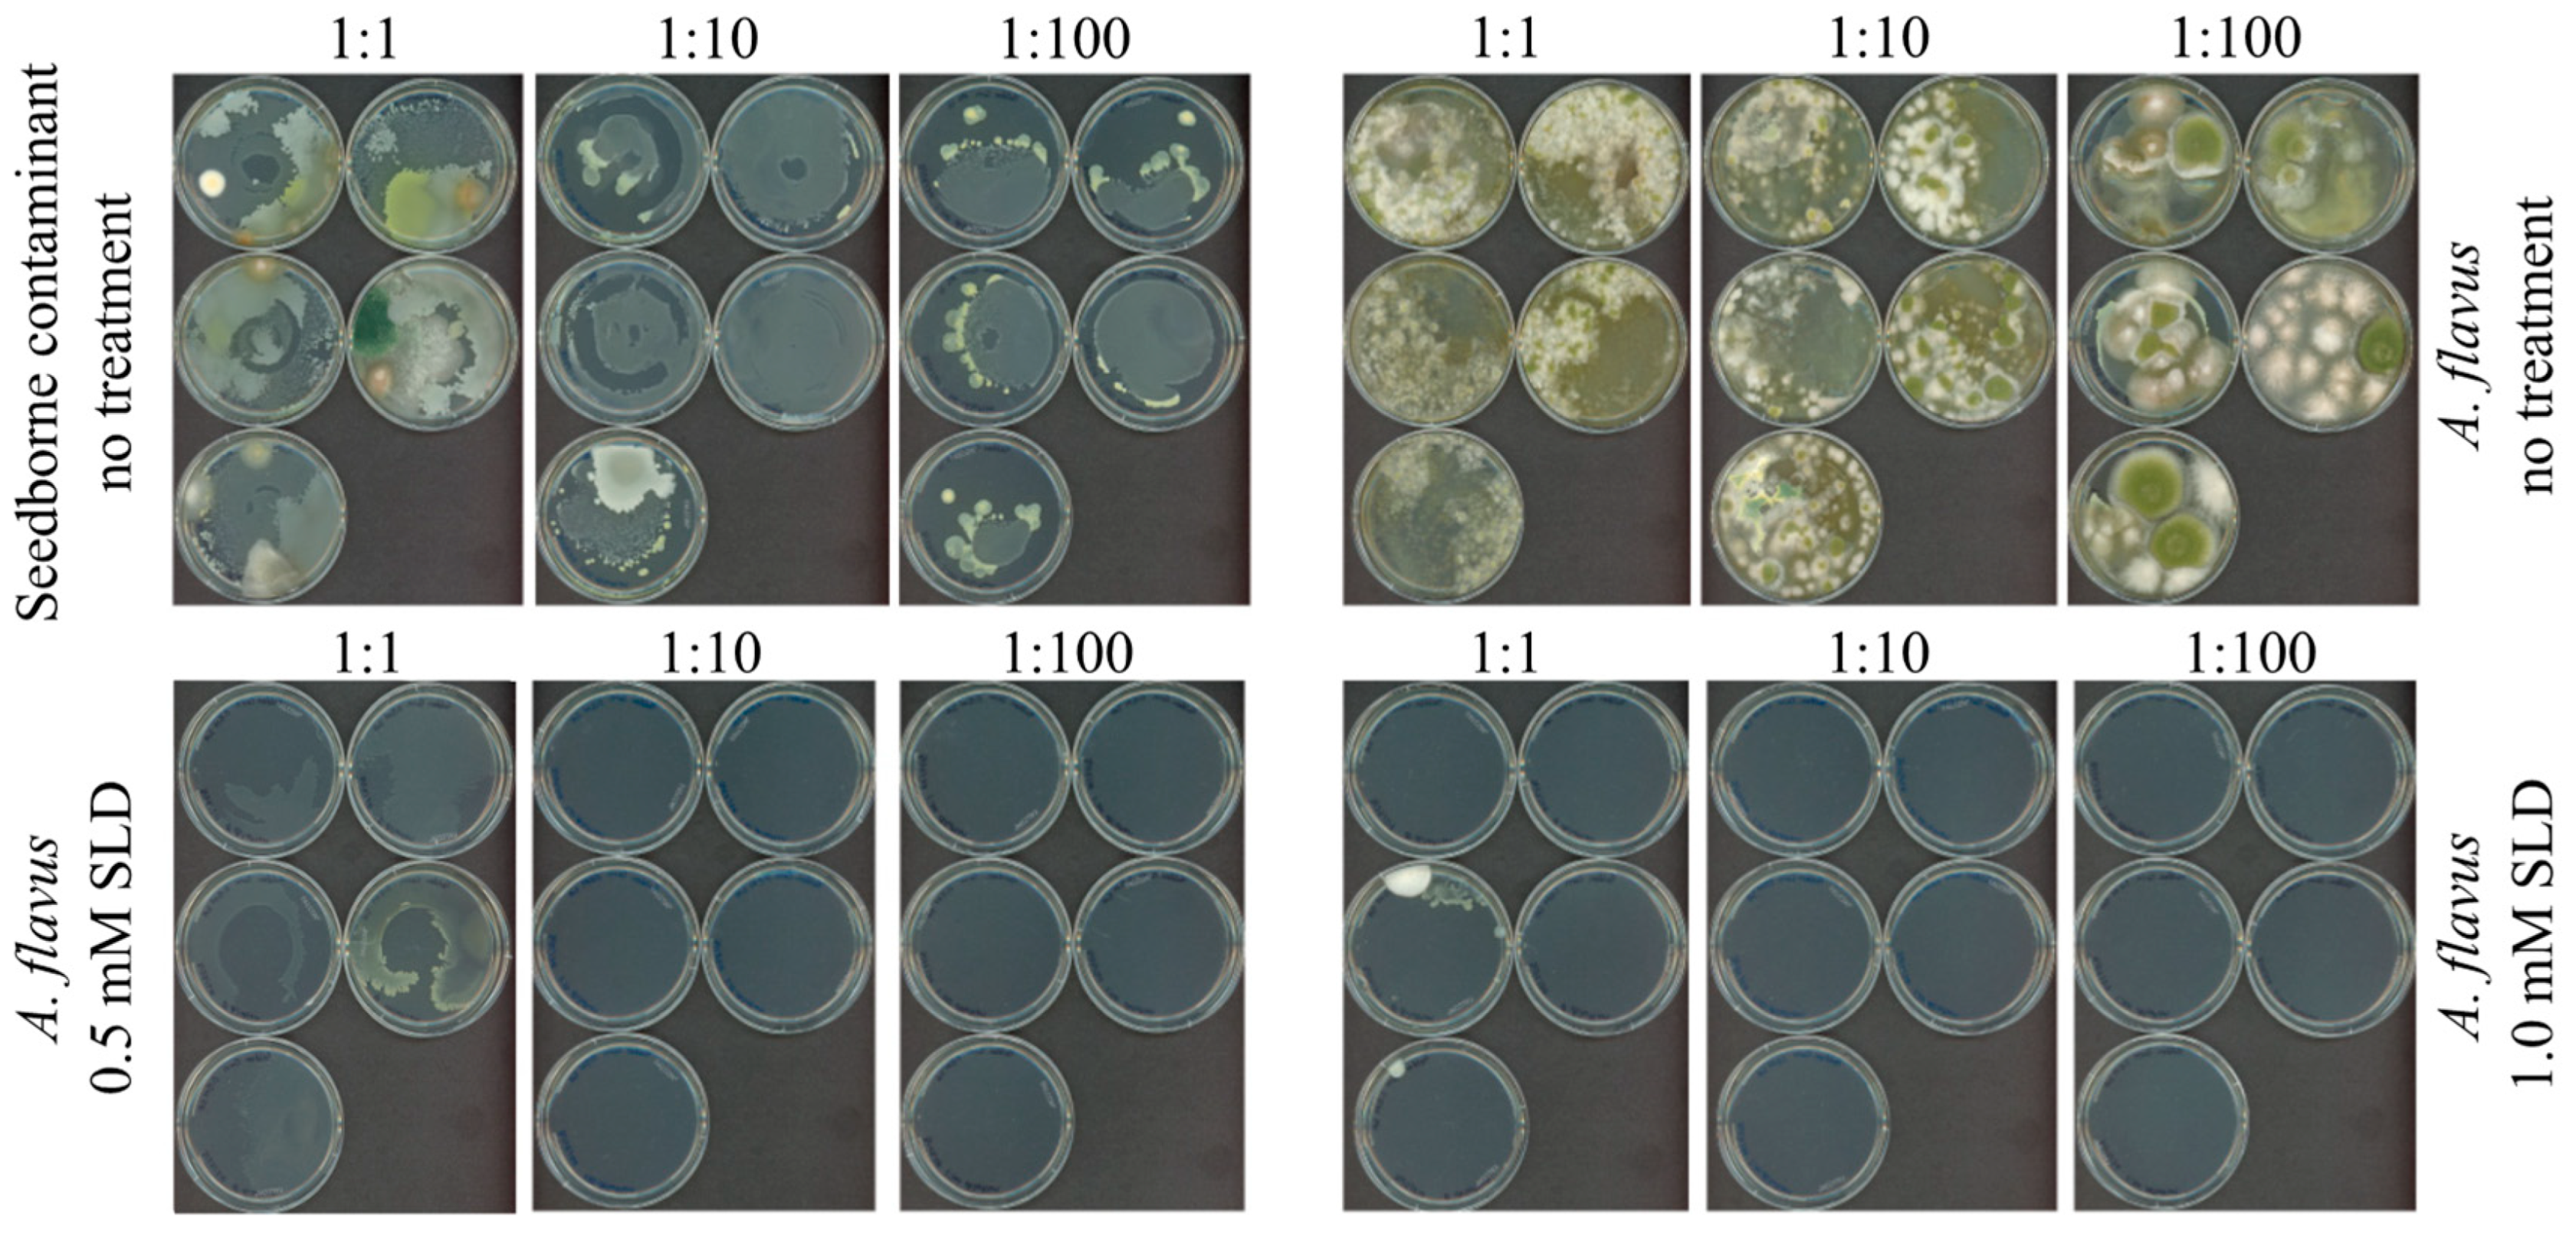
Applsci 14 10000 g004
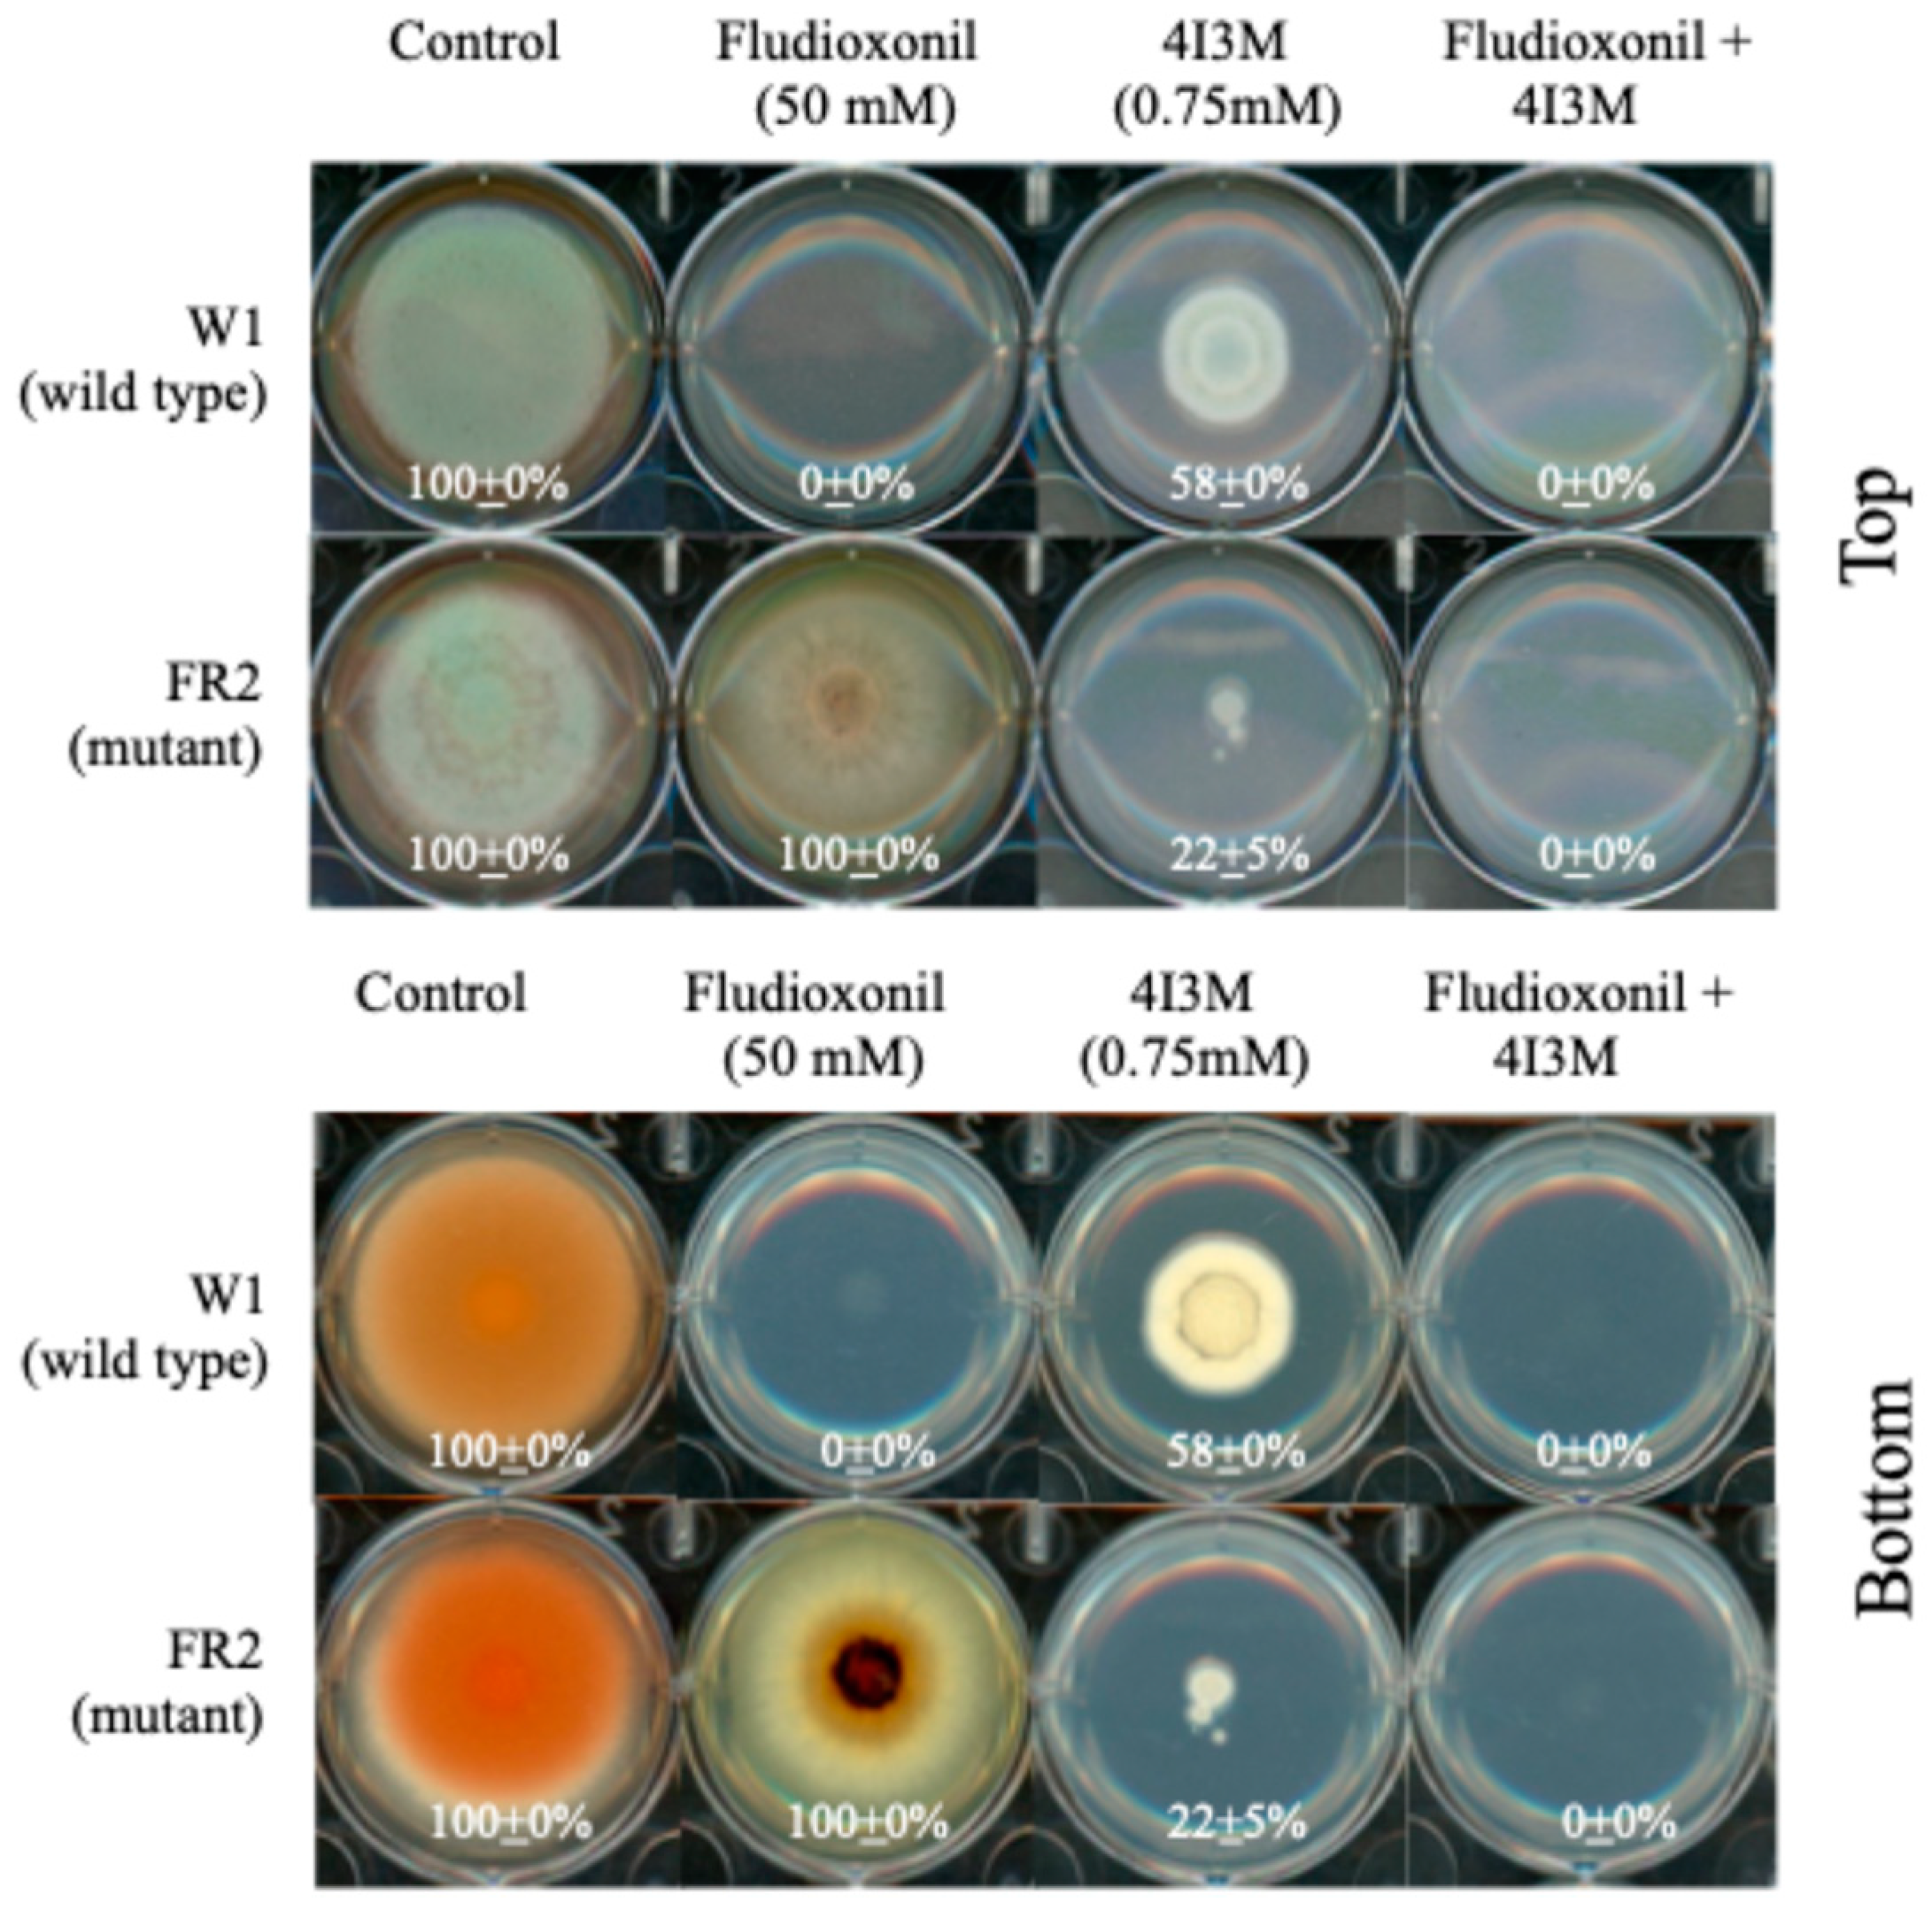
Applsci 14 10000 g006

The Inhibitory Activity of Salicylaldehyde Compounds on Aspergillus Species and Their Effects on Aflatoxin Production and Crop Seed Germination
Abstract
Featured Application
Abstract
1. Introduction
2. Materials and Methods
2.1. Chemicals and Microorganisms
2.2. Corn and Pistachio Kernels
2.3. Antifungal Assay
2.3.1. Petri Plate Assay on Segmented Dishes: Salicylaldehyde (SLD; Fumigant)
2.3.2. Raised Bed Assay (Large Scale Testing): SLD (Fumigant)
2.3.3. Petri Plate Assay on PDA Plates: 4-Isopropyl-3-Methylphenol (4I3M; Non-Fumigant)
2.4. AF Analysis; HPLC
2.5. Overcoming FLU Tolerance of Mitogen-Activated Protein Kinase (MAPK) Mutants of P. expansum
2.6. Statistical Analysis
3. Results and Discussion
3.1. Effects of Sub-Lethal Concentrations of NP/Derivatives on AF Production: A. flavus
3.2. Effects of Sub-Lethal Concentrations of NP/Derivatives on AF Production: A. parasiticus
3.3. Use of Salicylaldehyde (SLD) as an Antifungal Agent Targeting Corn Kernels: Petriplate Analysis (Small Scale)
3.4. Use of SLD as an Antifungal Agent on Corn Kernels: Raised Bed Analysis (Large Scale)
3.5. Use of 4-Isopropyl-3-Methylphenol (4I3M) as an Antifungal and Anti-Aflatoxigenic Agent on Corn Kernels
3.6. Overcoming Fludioxonil Tolerance of Mitogen-Activated Protein Kinase (MAPK) Mutants of P. expansum by 4I3M
Supplementary Materials
Author Contributions
Funding
Institutional Review Board Statement
Informed Consent Statement
Data Availability Statement
Acknowledgments
Conflicts of Interest
References
- Davies, C.R.; Wohlgemuth, F.; Young, T.; Violet, J.; Dickinson, M.; Sanders, J.-W.; Vallieres, C.; Avery, S.V. Evolving challenges and strategies for fungal control in the food supply chain. Fungal Biol. Rev. 2021, 36, 15–26. [Google Scholar] [CrossRef] [PubMed]
- Fones, H.N.; Bebber, D.P.; Chaloner, T.M.; Kay, W.T.; Steinberg, G.; Gurr, S.J. Threats to global food security from emerging fungal and oomycete crop pathogens. Nat. Food 2020, 1, 332–342. [Google Scholar] [CrossRef] [PubMed]
- Ali, M.E.; Gunn, M.; Stackhouse, T.; Waliullah, S.; Guo, B.; Culbreath, A.; Brenneman, T. Sensitivity of Aspergillus flavus isolates from peanut seeds in Georgia to azoxystrobin, a quinone outside inhibitor (QoI) fungicide. J. Fungi 2021, 7, 284. [Google Scholar] [CrossRef] [PubMed]
- Arnold, C.J.; Hahn, E.A.; Whetten, R.; Chartrain, L.; Cheema, J.; Brown, J.K.M.; Cowger, C. Multiple routes to fungicide resistance: Interaction of Cyp51 gene sequences, copy number and expression. Mol. Plant Pathol. 2024, 25, e13498. [Google Scholar] [CrossRef]
- Dorigan, A.F.; Moreira, S.I.; da Silva Costa Guimarães, S.; Cruz-Magalhães, V.; Alves, E. Target and non-target site mechanisms of fungicide resistance and their implications for the management of crop pathogens. Pest Manag. Sci. 2023, 79, 4731–4753. [Google Scholar] [CrossRef]
- Gao, Y.; Guo, Y.; Wang, L.; Guo, L.; Shi, B.; Zhu, L.; Wang, J.; Kim, Y.M.; Wang, J. Tebuconazole exacerbates co-occurrence and horizontal transfer of antibiotic resistance genes. Pestic. Biochem. Physiol. 2024, 204, 106026. [Google Scholar] [CrossRef]
- McLaughlin, M.S.; Roy, M.; Abbasi, P.A.; Carisse, O.; Yurgel, S.N.; Ali, S. Why do we need alternative methods for fungal disease management in plants? Plants 2023, 12, 3822. [Google Scholar] [CrossRef]
- Seress, D.; Molnár, O.; Matolcsi, F.; Pintye, A.; Kovács, G.M.; Németh, M.Z. Development and implementation of a novel caps assay reveals high prevalence of a boscalid resistance marker and its co-occurrence with an azole resistance marker in Erysiphe necator. Plant Dis. 2024, 108, 2607–2614. [Google Scholar] [CrossRef]
- Ellner, F.M. Results of long-term field studies into the effect of strobilurin containing fungicides on the production of mycotoxins in several winter wheat varieties. Mycotoxin Res. 2005, 21, 112–115. [Google Scholar] [CrossRef]
- Li, C.; Liu, C. Enantioselective effect of chiral fungicide prothioconazole on Fusarium graminearum: Fungicidal activity and DON biosynthesis. Environ. Pollut. 2022, 307, 119553. [Google Scholar] [CrossRef]
- Nazareth, T.d.M.; Soriano Pérez, E.; Luz, C.; Meca, G.; Quiles, J.M. Comprehensive review of aflatoxin and ochratoxin a dynamics: Emergence, toxicological impact, and advanced control strategies. Foods 2024, 13, 1920. [Google Scholar] [CrossRef] [PubMed]
- Kumar, P.; Mahato, D.K.; Kamle, M.; Mohanta, T.K.; Kang, S.G. Aflatoxins: A global concern for food safety, human health and their management. Front. Microbiol. 2017, 7. [Google Scholar] [CrossRef] [PubMed]
- Peraica, M.; Radić, B.; Lucić, A.; Pavlović, M. Toxic effects of mycotoxins in humans. Bull. World Health Organ. 1999, 77, 754–766. [Google Scholar] [PubMed]
- International Agency for Research on Cancer (IARC). Monographs on the Evaluation of Carcinogenic Risks to Humans: Chemical Agents and Related Occupations. A Review of Human Carcinogens; International Agency for Research on Cancer (IARC): Lyon, France, 2012; Volume 100.
- USDA, Agricultural Marketing Service. Mycotoxin Program. Available online: https://www.ams.usda.gov/services/lab-testing/mycotoxins (accessed on 24 October 2024).
- Dohlman, E. Mycotoxin Hazards and Regulations: Impacts on Food and Animal Feed Crop Trade; Agricultural Economics Report AER-828; USDA, Economic Research Service: Wahtington, DC, USA, 2003. Available online: https://www.ers.usda.gov/webdocs/publications/41603/15640_aer828h_1_.pdf?v=0 (accessed on 24 October 2024).
- U.S. Food and Drug Administration (FDA). Mycotoxins. Available online: https://www.fda.gov/food/natural-toxins-food/mycotoxins (accessed on 24 October 2024).
- Donnelly, R.; Elliott, C.; Zhang, G.; Baker, B.; Meneely, J. Understanding current methods for sampling of aflatoxins in corn and to generate a best practice framework. Toxins 2022, 14, 819. [Google Scholar] [CrossRef] [PubMed]
- Jayaratne, W.M.S.C.; Abeyratne, A.H.M.A.K.; De Zoysa, H.K.S.; Dissanayake, D.M.R.B.N.; Bamunuarachchige, T.C.; Waisundara, V.Y.; Chang, S. Detection and quantification of Aflatoxin B1 in corn and corn-grown soils in the district of Anuradhapura, Sri Lanka. Heliyon 2020, 6, e05319. [Google Scholar] [CrossRef] [PubMed]
- Soares Mateus, A.R.; Barros, S.; Pena, A.; Sanches Silva, A. Mycotoxins in pistachios (Pistacia vera L.): Methods for determination, occurrence, decontamination. Toxins 2021, 13, 682. [Google Scholar] [CrossRef]
- Doster, M.A.; Michailides, T.J. Aspergillus molds and aflatoxins in pistachio nuts in California. Phytopathology 1994, 84, 583–590. [Google Scholar] [CrossRef]
- Jalili, M.; Jinap, S.; Noranizan, A. Effect of gamma radiation on reduction of mycotoxins in black pepper. Food Control 2010, 21, 1388–1393. [Google Scholar] [CrossRef]
- Wang, B.; Mahoney, N.E.; Pan, Z.; Khir, R.; Wu, B.; Ma, H.; Zhao, L. Effectiveness of pulsed light treatment for degradation and detoxification of aflatoxin B1 and B2 in rough rice and rice bran. Food Control 2016, 59, 461–467. [Google Scholar] [CrossRef]
- Chen, R.; Ma, F.; Li, P.-W.; Zhang, W.; Ding, X.-X.; Zhang, Q.; Li, M.; Wang, Y.-R.; Xu, B.-C. Effect of ozone on aflatoxins detoxification and nutritional quality of peanuts. Food Chem. 2014, 146, 284–288. [Google Scholar] [CrossRef]
- Hontanaya, C.; Meca, G.; Luciano, F.B.; Mañes, J.; Font, G. Inhibition of aflatoxin B1, B2, G1 and G2 production by Aspergillus parasiticus in nuts using yellow and oriental mustard flours. Food Control 2015, 47, 154–160. [Google Scholar] [CrossRef]
- Wang, W.; Lawrence, K.C.; Ni, X.; Yoon, S.-C.; Heitschmidt, G.W.; Feldner, P. Near-infrared hyperspectral imaging for detecting Aflatoxin B1 of maize kernels. Food Control 2015, 51, 347–355. [Google Scholar] [CrossRef]
- Accinelli, C.; Abbas, H.K.; Little, N.S.; Kotowicz, J.K.; Shier, W.T. Biological control of aflatoxin production in corn using non-aflatoxigenic Aspergillus flavus administered as a bioplastic-based seed coating. Crop Prot. 2018, 107, 87–92. [Google Scholar] [CrossRef]
- Garcia-Lopez, M.T.; Meca, E.; Jaime, R.; Puckett, R.D.; Michailides, T.J.; Moral, J. Sporulation and dispersal of the biological control agent Aspergillus flavus AF36 under field conditions. Phytopathology 2024, 114, 1118–1125. [Google Scholar] [CrossRef] [PubMed]
- Peles, F.; Sipos, P.; Kovács, S.; Győri, Z.; Pócsi, I.; Pusztahelyi, T. Biological control and mitigation of aflatoxin contamination in commodities. Toxins 2021, 13, 104. [Google Scholar] [CrossRef]
- Markoglou, A.N.; Doukas, E.G.; Malandrakis, A.A. Effect of anilinopyrimidine resistance on aflatoxin production and fitness parameters in Aspergillus parasiticus Speare. Int. J. Food Microbiol. 2011, 146, 130–136. [Google Scholar] [CrossRef]
- Doukas, E.G.; Markoglou, A.N.; Vontas, J.G.; Ziogas, B.N. Effect of DMI-resistance mechanisms on cross-resistance patterns, fitness parameters and aflatoxin production in Aspergillus parasiticus Speare. Fungal Genet. Biol. 2012, 49, 792–801. [Google Scholar] [CrossRef]
- Kojima, K.; Takano, Y.; Yoshimi, A.; Tanaka, C.; Kikuchi, T.; Okuno, T. Fungicide activity through activation of a fungal signalling pathway. Mol. Microbiol. 2004, 53, 1785–1796. [Google Scholar] [CrossRef]
- Kamali, M.; Ghaderi, A.; Tamimi, P.; Firooz, A.; Nasiri Kashani, M.; Ayatollahi, A.; Valizadeh, F.; Fattahi, M.; Fattahi, M. Reactive oxygen species-inducing itraconazole and its anti-biofilm activity against resistant Candida parapsilosis sensu lato biofilm cells isolated from patients with recalcitrant onychomycosis. Arch. Dermatol. Res. 2024, 316, 642. [Google Scholar] [CrossRef]
- Kim, J.H.; Chan, K.L.; Mahoney, N.; Campbell, B.C. Antifungal activity of redox-active benzaldehydes that target cellular antioxidation. Ann. Clin. Microbiol. Antimicrob. 2011, 10, 23. [Google Scholar] [CrossRef]
- Lee, K.-T.; Kwon, H.; Lee, D.; Bahn, Y.-S. A nudix hydrolase protein, Ysa1, regulates oxidative stress response and antifungal drug susceptibility in Cryptococcus neoformans. Mycobiology 2014, 42, 52–58. [Google Scholar] [CrossRef] [PubMed]
- Sasse, C.; Bastakis, E.; Bakti, F.; Höfer, A.M.; Zangl, I.; Schüller, C.; Köhler, A.M.; Gerke, J.; Krappmann, S.; Finkernagel, F.; et al. Induction of Aspergillus fumigatus zinc cluster transcription factor OdrA/Mdu2 provides combined cellular responses for oxidative stress protection and multiple antifungal drug resistance. mBio 2023, 14, e02628-23. [Google Scholar] [CrossRef] [PubMed]
- Barrett, D. From natural products to clinically useful antifungals. Biochim. Biophys. Acta. 2002, 1587, 224–233. [Google Scholar] [CrossRef] [PubMed]
- Jacob, M.R.; Walker, L.A. Natural Products and Antifungal Drug Discovery. In Antifungal Agents: Methods and Protocols; Ernst, E.J., Rogers, P.D., Eds.; Humana Press: Totowa, NJ, USA, 2005. [Google Scholar] [CrossRef]
- Guillén, F.; Evans, C.S. Anisaldehyde and veratraldehyde acting as redox cycling agents for H2O2 production by Pleurotus eryngii. Appl. Environ. Microbiol. 1994, 60, 2811–2817. [Google Scholar] [CrossRef] [PubMed]
- Jacob, C. A scent of therapy: Pharmacological implications of natural products containing redox-active sulfur atoms. Nat. Prod. Rep. 2006, 23, 851–863. [Google Scholar] [CrossRef]
- EFSA Panel on Additives and Products or Substances used in Animal Feed (FEEDAP); Bampidis, V.; Azimonti, G.; Bastos, M.d.L.; Christensen, H.; Dusemund, B.; Durjava, M.F.; Kouba, M.; López-Alonso, M.; López Puente, S.; et al. Safety and efficacy of a feed additive consisting of a preparation of carvacrol, thymol, D-carvone, methyl salicylate and L-menthol (Biomin® DC-P) for all poultry species (Biomin GmbH). EFSA J. 2022, 20, e07429. [Google Scholar] [CrossRef]
- Jayashree, T.; Subramanyam, C. Oxidative stress as a prerequisite for aflatoxin production by Aspergillus parasiticus. Free Radic. Biol. Med. 2000, 29, 981–985. [Google Scholar] [CrossRef]
- Sadhasivam, S.; Shapiro, O.H.; Ziv, C.; Barda, O.; Zakin, V.; Sionov, E. Synergistic inhibition of mycotoxigenic fungi and mycotoxin production by combination of pomegranate peel extract and azole fungicide. Front. Microbiol. 2019, 10, 1919. [Google Scholar] [CrossRef]
- U.S. Food and Drug Administration (FDA). Substances Added to Food (Formerly EAFUS). Available online: https://www.fda.gov/food/food-additives-petitions/substances-added-food-formerly-eafus (accessed on 22 October 2024).
- Benkerroum, N. Aflatoxins: Producing-molds, structure, health issues and incidence in Southeast Asian and sub-Saharan African countries. Int. J. Environ. Res. Public Health 2020, 17, 1215. [Google Scholar] [CrossRef]
- Shabeer, S.; Asad, S.; Jamal, A.; Ali, A. Aflatoxin contamination, its impact and management strategies: An updated review. Toxins 2022, 14, 307. [Google Scholar] [CrossRef]
- U.S. Food and Drug Administration (FDA). GRAS Notice Inventory. Available online: https://www.fda.gov/food/generally-recognized-safe-gras/gras-notice-inventory (accessed on 22 October 2024).
- USDA, Agricultural Research Service (ARS). ARS Culture Collection. Available online: https://nrrl.ncaur.usda.gov/ (accessed on 22 October 2024).
- Li, H.X.; Xiao, C.L. Characterization of fludioxonil-resistant and pyrimethanil-resistant phenotypes of Penicillium expansum from apple. Phytopathology 2008, 98, 427–435. [Google Scholar] [CrossRef] [PubMed]
- U.S. Food and Drug Administration (FDA). Substances Added to Food (Formerly EAFUS). Dimethyl Sulfoxide. Available online: https://www.hfpappexternal.fda.gov/scripts/fdcc/index.cfm?set=FoodSubstances&id=DIMETHYLSULFOXIDE (accessed on 22 October 2024).
- Hua, S.S.T.; Parfitt, D.E.; Sarreal, S.B.L.; Sidhu, G. Dual culture of atoxigenic and toxigenic strains of Aspergillus flavus to gain insight into repression of aflatoxin biosynthesis and fungal interaction. Mycotoxin Res. 2019, 35, 381–389. [Google Scholar] [CrossRef] [PubMed]
- Kirkman, T.W. Statistics to Use. Available online: http://www.physics.csbsju.edu/stats/ (accessed on 28 August 2024).
- EFSA Panel on Additives and Products or Substances used in Animal Feed (FEEDAP); Bampidis, V.; Azimonti, G.; de Lourdes Bastos, M.; Christensen, H.; Dusemund, B.; Kouba, M.; Kos Durjava, M.; López-Alonso, M.; López Puente, S.; et al. Safety and efficacy of Biomin® DC-P as a zootechnical feed additive for chickens for fattening, chickens reared for laying and minor avian species to the point of lay. EFSA J. 2019, 17, e05724. [Google Scholar] [CrossRef] [PubMed]
- Axe, A.; Bradshaw, D. Antibacterial Composition Comprising 4-Isopropyl-3-Methylphenol and Zinc Ions. U.S. Patent Application Publication Pub. No. 20120039820, 16 February 2012. [Google Scholar]
- Choi, W.-S.; Jang, S.-H.; Jang, D.-Y.; Choi, K.-G.; Lee, B.-H.; Kim, T.-J.; Jung, B.-J. Antifungal activities for derivatives of 4-isopropyl-3-methylphenol and 5-isopropyl-3-methylphenol against plant pathogenic fungi. Korean J. Pest. Sci. 2006, 10, 249–261. [Google Scholar]
- Abe, Y.; Okazaki, Y.; Dainobu, K.; Matsuo, K.; Ishida, H.; Tsuga, K. Antimicrobial effects of viscous mouthrinses containing cetylpyridinium chloride and isopropyl methylphenol. Am. J. Dent. 2020, 33, 235–238. [Google Scholar]
- Ohara, H.; Odanaka, K.; Shiine, M.; Hayasaka, M. Antimicrobial effect of oral care gel containing hinokitiol and 4-isopropyl-3-methylphenol against intraoral pathogenic microorganisms. PLoS ONE 2023, 18, e0283295. [Google Scholar] [CrossRef]
- Korenaga, A.; Miyaoka, T.; Asami, H.; Yamagami, Y.; Yoshii, M.; Tanaka, S.; Nagao, T. Synergetic inhibitory effect of isopropyl methylphenol-based agents on biofilm formation by Streptococcus mutans. PLoS ONE 2024, 19, e0310926. [Google Scholar] [CrossRef]
- Kim, J.H.; Chan, K.; Faria, N.C.G.; Martins, M.d.L.; Campbell, B. Targeting the oxidative stress response system of fungi with redox-potent chemosensitizing agents. Front. Microbiol. 2012, 3, 88. [Google Scholar] [CrossRef]
- Abdin, M.Z.; Ahmad, M.M.; Javed, S. Advances in molecular detection of Aspergillus: An update. Arch. Microbiol. 2010, 192, 409–425. [Google Scholar] [CrossRef]
- Yu, J.; Chang, P.-K.; Ehrlich, K.C.; Cary, J.W.; Bhatnagar, D.; Cleveland, T.E.; Payne, G.A.; Linz, J.E.; Woloshuk, C.P.; Bennett, J.W. Clustered pathway genes in aflatoxin biosynthesis. Appl. Environ. Microbiol. 2004, 70, 1253–1262. [Google Scholar] [CrossRef]
- EFSA Panel on Additives and Products or Substances used in Animal Feed (FEEDAP). Scientific opinion on the safety and efficacy of benzyl alcohols, aldehydes, acids, esters and acetals (chemical group 23) when used as flavourings for all animal species. EFSA J. 2012, 10, 2785. [Google Scholar] [CrossRef]
- National Center for Biotechnology Information. PubChem Compound Summary for CID 6998, Salicylaldehyde. Available online: https://pubchem.ncbi.nlm.nih.gov/compound/salicylaldehyde (accessed on 16 September 2024).
- U.S. Food and Drug Administration (FDA). Substances Added to Food (Formerly EAFUS). Salicylaldehyde. Available online: https://www.cfsanappsexternal.fda.gov/scripts/fdcc/?set=FoodSubstances&id=SALICYLALDEHYDE (accessed on 16 September 2024).
- Haviland, D.R.; Baldwin, R.A.; Hembree, K.J.; Michailides, T.J.; Westerdahl, B.B.; Beede, R.H.; Daane, K.M.; Fukuda, T.A.; Kallsen, C.E.; Shrestha, A.; et al. UC IPM Pest Management Guidelines: Pistachio; UC ANR Publication 3461: Davis, CA, Revised Continuously. Available online: https://ipm.ucanr.edu/agriculture/pistachio/ (accessed on 24 September 2024).
- Han, U.; Lee, Y.-G.; Byeon, J.; Chon, K.; Cho, S.-K. Mitigation of benzoic acid-driven autotoxicity in waste nutrient solution using O3 and O3/H2O2 treatments: Seed germination and root growth of Lactuca sativa L. Environ. Pollut. 2023, 331, 121930. [Google Scholar] [CrossRef] [PubMed]
- Ji, X.; Wang, W.; Li, J.; Liu, L.; Yue, H. Oxidation-reduction process of Arabidopsis thaliana roots induced by bisphenol compounds based on RNA-seq analysis. J. Environ. Sci. 2025, 148, 188–197. [Google Scholar] [CrossRef]
- Sun, M.; Sun, S.; Jia, Z.; Ma, W.; Mao, C.; Ou, C.; Wang, J.; Zhang, H.; Hong, L.; Li, M.; et al. Genome-wide analysis and expression profiling of glutathione reductase gene family in oat (Avena sativa) indicate their responses to abiotic stress during seed imbibition. Int. J. Mol. Sci. 2022, 23, 11650. [Google Scholar] [CrossRef] [PubMed]
- Wang, Z.; Mao, Y.; Liang, L.; Pedro, G.-C.; Zhi, L.; Li, P.; Hu, X. HFR1 antagonizes ABI4 to coordinate cytosolic redox status for seed germination under high-temperature stress. Physiol. Plant. 2024, 176, e14490. [Google Scholar] [CrossRef]
- Environmental Protection Agency (EPA). Salicylaldehyde; Exemption from the Requirement of a Tolerance. 81 FR 17611. Available online: https://www.federalregister.gov/d/2016-07085 (accessed on 20 September 2024).
- Clinical and Laboratory Standards Institute (CLSI). Reference Method for Broth Dilution Antifungal Susceptibility Testing of Filamentous Fungi: Approved Standard-Second Edition; CLSI Document M38-A2; Clinical and Laboratory Standards Institute: Wayne, PA, USA, 2008. [Google Scholar]
- Odds, F.C. Synergy, antagonism, and what the chequerboard puts between them. J. Antimicrob. Chemother. 2003, 52, 1. [Google Scholar] [CrossRef]
- Kim, J.H.; Chan, K.; Ford, D.; Sarreal, S.B.L.; Palumbo, J. Baseline Determination of Azole-Resistant Aspergilli in California Farms: Correlation Between Azole Resistance and Aflatoxin Production. Available online: https://scimeetings.acs.org/exhibit/Baseline-determination-azole-resistant-aspergilli/3921436 (accessed on 22 October 2024).

| NPs/Derivatives | Test Concentrations (mM) | A. flavus | A. parasiticus |
|---|---|---|---|
| 2,3-Dihydroxybenzaldehyde (2,3-D) | 0.1, 0.2 | B1, B2 | - 1 |
| 2,4-Dihydroxybenzaldehyde (2,4-D) | 0.5, 1.0 | - 1 | G2 |
| 2,5-Dihydroxybenzaldehyde (2,5-D) | 0.5, 1.0 | B1, B2 | - 1 |
| 3,5-Dimethoxybenzaldehyde (3,5-D) | 0.5, 0.75 | B1, B2 | G2 |
| 2-Hydroxy-4-methoxybenzaldehyde (2H4M) | 0.1, 0.2 | B2 | - 1 |
| 2-Hydroxy-5-methoxybenzaldehyde (2H5M) | 0.1, 0.2 | B1, B2 | G1 |
| Salicylaldehyde (SLD) | 0.5, 1.0 | B2 | - 2 |
| Salicylic acid (SA) | 0.5, 1.0 | B1 | G1, G2 |
| 4-Isopropyl-3-methylphenol (4I3M) | 0.2, 0.4 | - 1 | - 1 |
| Thymol (THY) | 0.2, 0.4 | B2 | B1, B2, G1, G2 |
| Carvacrol (CARV) | 0.2, 0.4 | B2 | B2, G2 |
| 4-Methylcinnamic acid (4-MEC) | 0.5, 1.0 | B2 | - 1 |
| 4-Methoxycinnamic acid (4-MOC) | 0.5, 1.0 | - 1 | G1, G2 |
| 1 Day | 2 Day | 3 Day | |||||||
|---|---|---|---|---|---|---|---|---|---|
| SLD (mM) | # Seed Germinated | # Af Contaminated | # Seedborne Contaminated | # Seed Germinated | # Af Contaminated | # Seedborne Contaminated | # Seed Germinated | # Af Contaminated | # Seedborne Contaminated |
| 0.0 (Seed only) 1 | 10 | 0 | 10 | 10 | 0 | 10 | 10 | 0 | 10 |
| 0.0 (Seed only) 2 | 10 | 0 | 10 | 9 | 0 | 10 | 10 | 0 | 10 |
| 0.0 1 | 9 | 10 | 0 | 9 | 10 | 0 | 6 | 10 | 0 |
| 0.0 2 | 7 | 10 | 0 | 10 | 10 | 0 | 7 | 10 | 0 |
| 0.1 1 | 6 | 10 | 3 | 10 | 10 | 0 | 1 | 9 | 0 |
| 0.1 2 | 6 | 10 | 0 | 8 | 10 | 0 | 0 | 10 | 1 |
| 0.2 1 | 3 | 6 | 4 | 5 | 10 | 0 | 1 | 7 | 2 |
| 0.2 2 | 3 | 6 | 4 | 5 | 10 | 0 | 0 | 5 | 1 |
| 0.3 1 | 7 | 6 | 5 | 6 | 8 | 2 | 3 | 10 | 0 |
| 0.3 2 | 5 | 4 | 6 | 2 | 3 | 2 | 1 | 3 | 0 |
| 0.4 1 | 2 | 0 | 10 | 0 | 3 | 0 | 0 | 0 | 1 |
| 0.4 2 | 4 | 4 | 6 | 2 | 7 | 1 | 0 | 0 | 0 |
| 0.5 1 | 8 | 6 | 3 | 1 | 1 | 3 | 0 | 0 | 1 |
| 0.5 2 | 5 | 7 | 3 | 1 | 1 | 1 | 0 | 0 | 0 |
| 0.6 1 | 4 | 6 | 4 | 0 | 0 | 0 | 0 | 0 | 0 |
| 0.6 2 | 3 | 3 | 6 | 1 | 2 | 1 | 0 | 0 | 0 |
| 0.7 1 | 4 | 9 | 3 | 0 | 0 | 0 | 0 | 0 | 0 |
| 0.7 2 | 5 | 8 | 3 | 0 | 0 | 0 | 0 | 0 | 0 |
| 0.8 1 | 5 | 7 | 3 | 0 | 0 | 1 | 0 | 0 | 0 |
| 0.8 2 | 4 | 8 | 3 | 1 | 0 | 1 | 0 | 0 | 0 |
| 0.9 1 | 5 | 7 | 3 | 0 | 0 | 0 | 0 | 0 | 0 |
| 0.9 2 | 4 | 7 | 3 | 0 | 0 | 1 | 0 | 0 | 0 |
| 1.0 1 | 5 | 7 | 4 | 0 | 0 | 0 | 0 | 0 | 0 |
| 1.0 2 | 4 | 8 | 3 | 0 | 0 | 1 | 0 | 0 | 0 |
| Average | 4.9 | 6.8 | 3.6 | 2.8 | 3.9 | 0.6 | 0.9 | 2.9 | 0.3 |
| SD | 1.7 | 2.5 | 2.2 | 3.6 | 4.4 | 0.8 | 2.0 | 4.2 | 0.6 |
| p-value | - | - | - | 0.016 | 0.01 | 0.0001 | 0.0001 | 0.01 | 0.0001 |
Disclaimer/Publisher’s Note: The statements, opinions and data contained in all publications are solely those of the individual author(s) and contributor(s) and not of MDPI and/or the editor(s). MDPI and/or the editor(s) disclaim responsibility for any injury to people or property resulting from any ideas, methods, instructions or products referred to in the content. |
© 2024 by the authors. Licensee MDPI, Basel, Switzerland. This article is an open access article distributed under the terms and conditions of the Creative Commons Attribution (CC BY) license (https://creativecommons.org/licenses/by/4.0/).
Share and Cite
Kim, J.H.; Chan, K.L.; Hart-Cooper, W.M.; Ford, D.; Orcutt, K.; Sarreal, S.B.L.; Palumbo, J.D.; Orts, W.J. The Inhibitory Activity of Salicylaldehyde Compounds on Aspergillus Species and Their Effects on Aflatoxin Production and Crop Seed Germination. Appl. Sci. 2024, 14, 10000. https://doi.org/10.3390/app142110000
Kim JH, Chan KL, Hart-Cooper WM, Ford D, Orcutt K, Sarreal SBL, Palumbo JD, Orts WJ. The Inhibitory Activity of Salicylaldehyde Compounds on Aspergillus Species and Their Effects on Aflatoxin Production and Crop Seed Germination. Applied Sciences. 2024; 14(21):10000. https://doi.org/10.3390/app142110000
Chicago/Turabian StyleKim, Jong H., Kathleen L. Chan, William M. Hart-Cooper, DeAngela Ford, Kaydren Orcutt, Siov Bouy L. Sarreal, Jeffrey D. Palumbo, and William J. Orts. 2024. "The Inhibitory Activity of Salicylaldehyde Compounds on Aspergillus Species and Their Effects on Aflatoxin Production and Crop Seed Germination" Applied Sciences 14, no. 21: 10000. https://doi.org/10.3390/app142110000
APA StyleKim, J. H., Chan, K. L., Hart-Cooper, W. M., Ford, D., Orcutt, K., Sarreal, S. B. L., Palumbo, J. D., & Orts, W. J. (2024). The Inhibitory Activity of Salicylaldehyde Compounds on Aspergillus Species and Their Effects on Aflatoxin Production and Crop Seed Germination. Applied Sciences, 14(21), 10000. https://doi.org/10.3390/app142110000

